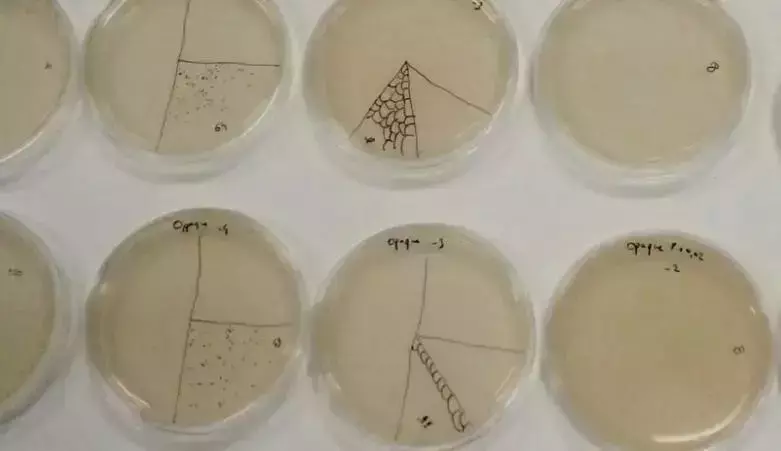
超乎你想像,性感模特的皮衣用真菌制作,新加坡用樹葉做面料

據《每日郵報》消息,有科學家開發出一種由真菌制成的純素皮革,其外觀和手感都與真皮別無二致。
圖片來源網絡
這種素皮革由位于舊金山的生物材料公司MycoWorks創造,素皮革由菌絲體制成——即在真菌上發現的管狀細絲。MycoWorks公司與專業的傳統皮革工匠密切合作,能把純素皮革做得像真皮一樣。
(圖:來源自網絡)
這種新材料比真正的(動物)皮革更符合道德規範,對環境的影響也更小。使用菌絲體制成的服裝是可生物降解的,有望制止“快速時尚”對環境帶來的破壞。
圖片來源網絡
菌絲體是真菌的無限可再生根部結構,而蘑菇是真菌的“果實”。通過對低成本的農業和林業副産品(如鋸末)進行升級改造,可以用真菌來生産皮革。而菌絲體生長的飼料(一團細長的真菌線),它們會長成片狀,幾周內就可以收獲真菌生物質。 公司還表示,其精細菌絲體(Fine Mycelium)專利技術複制了真皮皮革的外觀和手感,同時在強度和耐久性方面優于真皮。
(圖:來源自網絡)
以往的真皮,都是由動物制成的,通常來自牛、綿羊、羔羊、山羊、馬、水牛、豬,甚至海豹、鯨魚和鳄魚等水生動物。這些動物制成的皮革引發了道德問題,以及可能造成畜牧業相關的森林砍伐和溫室氣體排放,給環境帶來危害。
素食的思想流派不僅適用于無動物飲食,還適用于服裝和家具,或任何可能涉及動物試驗的東西。
(圖:來源自網絡)
新加坡也有不少人加入了環保面料革命的生力軍。60歲的許光裕兩年前創辦Nextevo環保面料公司,在印度尼西亞、泰國和新加坡有三家公司,專把農業廢棄的黃梨葉加工處理,變成紡織面料。
(圖:來源自網絡)
許光裕初時在汽車與重工機械業長達20幾年,後來在黃梨種植業擔任總裁近10年。他離職後,一度想進入生物質行業,後來跟椰子和香蕉業同行聊起,發現原來這麽多被丟棄或燒掉的種植廢料都是能再生成面料的寶藏。
許光裕跟泰國一家黃梨罐頭食品廠合資,直接跟農民購買黃梨葉。他與團隊過去兩年成功研發將黃梨葉變成紡織面料的程序。
他說:“我們先將黃梨葉切片,萃取出纖維後,進一步去除膠質和風幹後就得出像棉花球狀的纖維。我們把這纖維球交給第三方,幫我們融入天絲、有機棉等纖維,加強後紡成紗線。取回紗線後,我們才在自己的廠內織成面料。”
(圖:來源自網絡)
這些環保純素面料應用功能極大,能制成衣物、鞋、毛巾及裝飾家具等。 黃梨纖維所織成的面料柔滑且透氣,可媲美棉布,摸上去時手感清涼,更優于棉布。黃梨纖維能吸收和保留顔料,染出的顔色十分漂亮鮮活。該材料還得到了國際環保紡織協會(OEKO-TEX)的Standard 100認證,證明布料對嬰孩皮膚無害。
黃梨葉是黃梨種植業的副産品,不用特地另辟土地和資源來種,這已經很環保。食品商本來只取黃梨,葉子是廢棄物。向農民買下棄物,讓農民收入增加至少20%,能改善他們的生活。這真的是多贏!